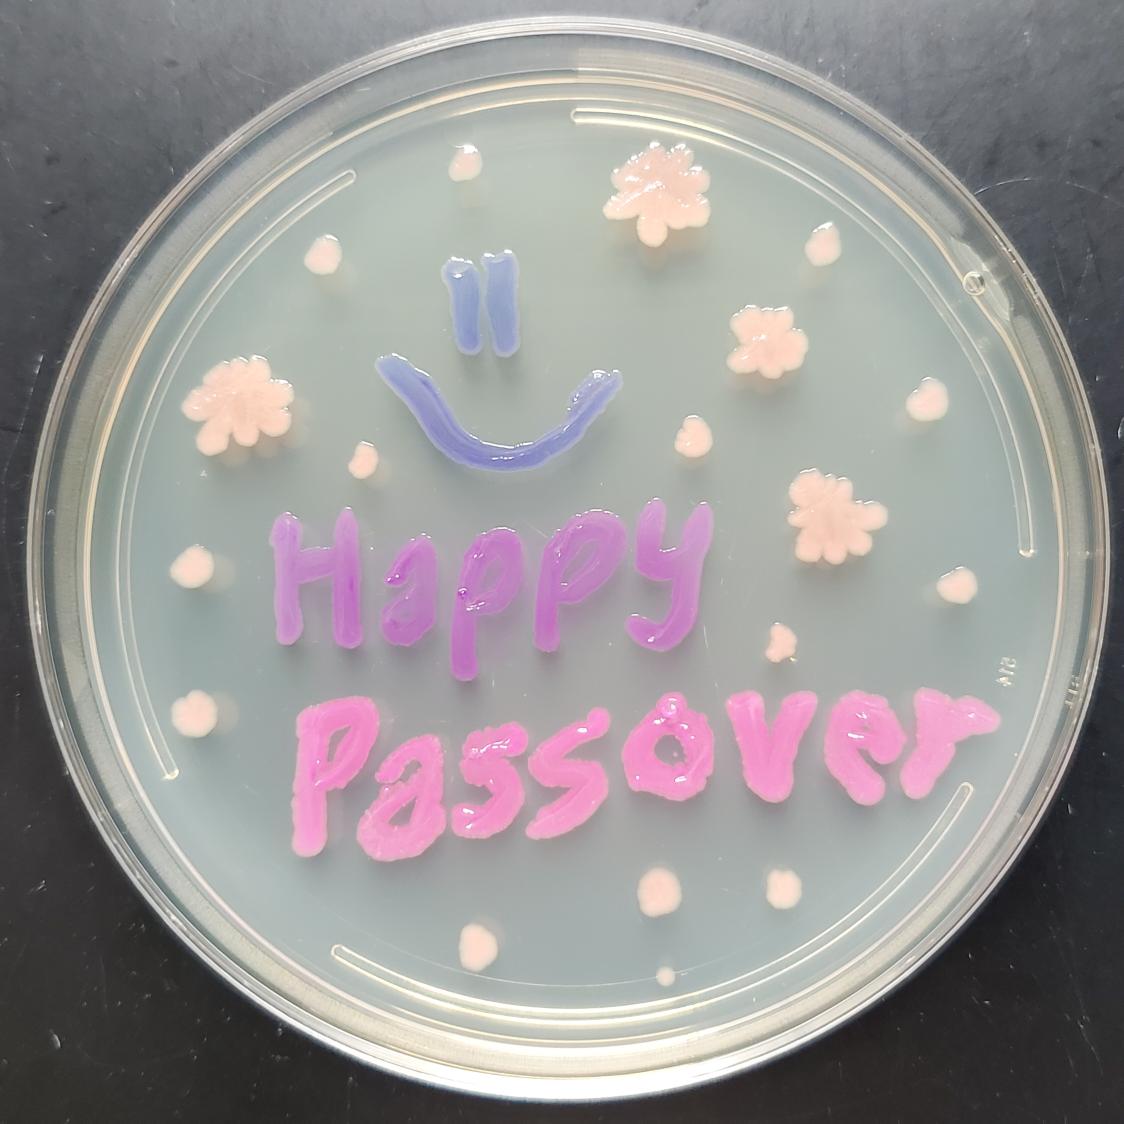
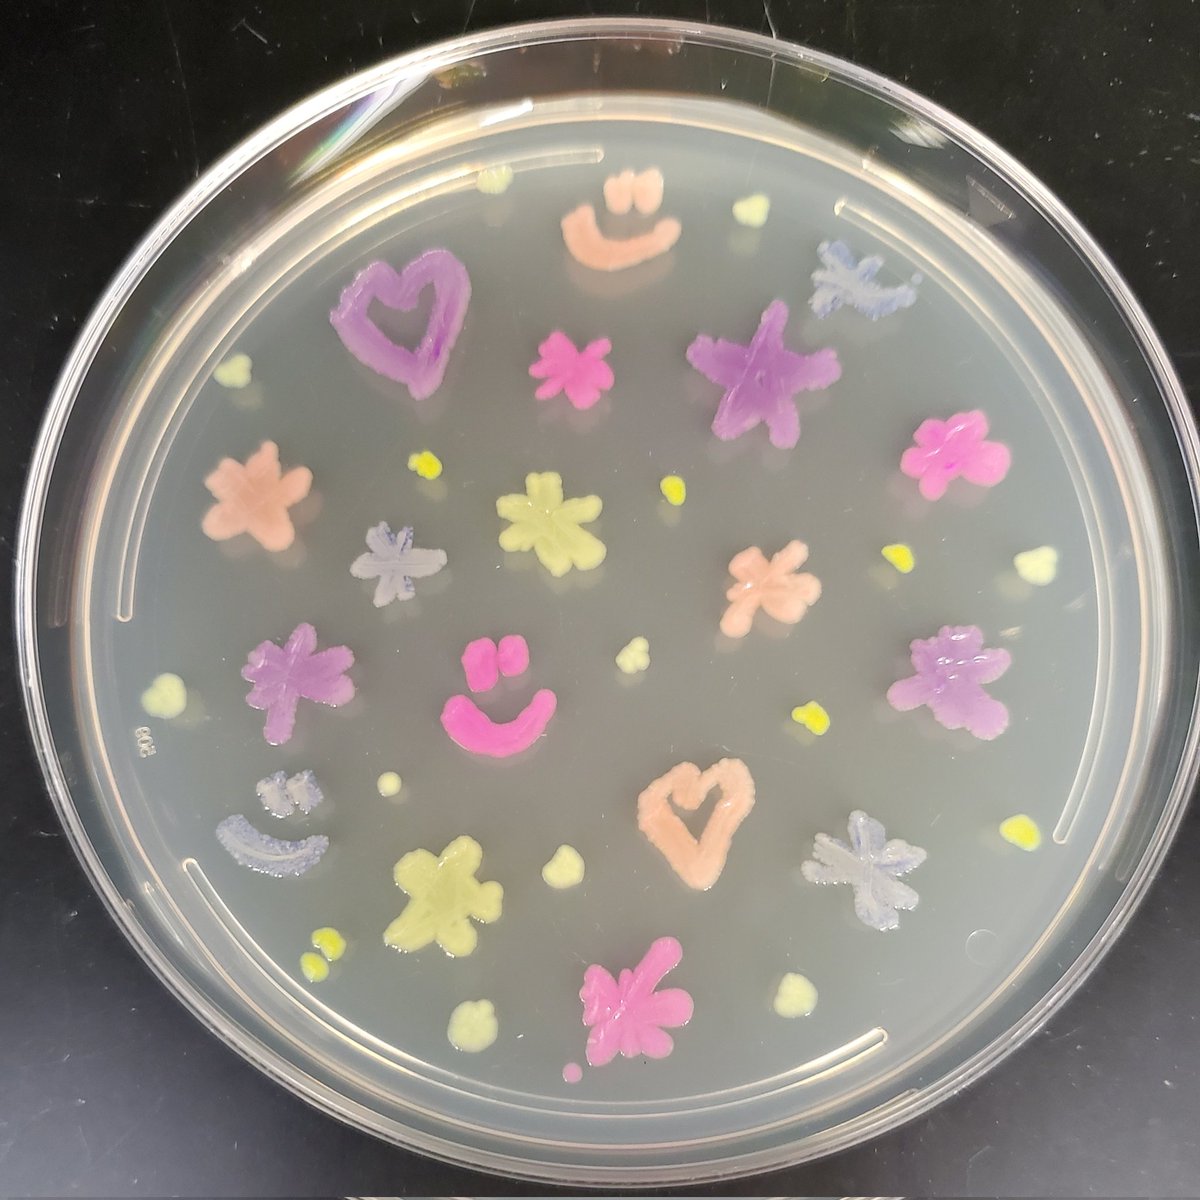
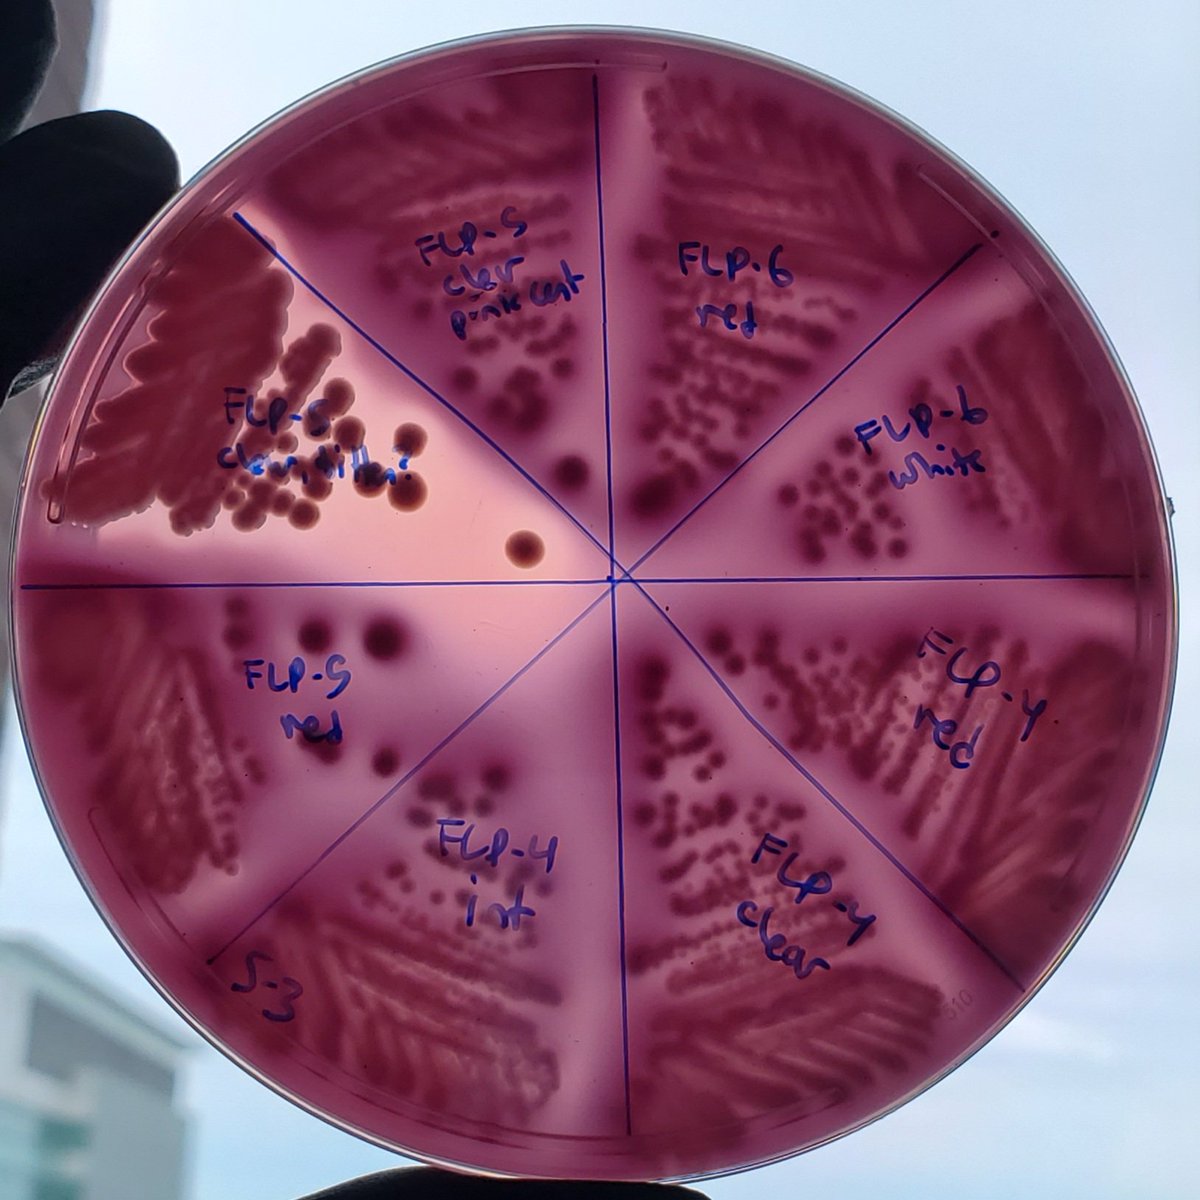
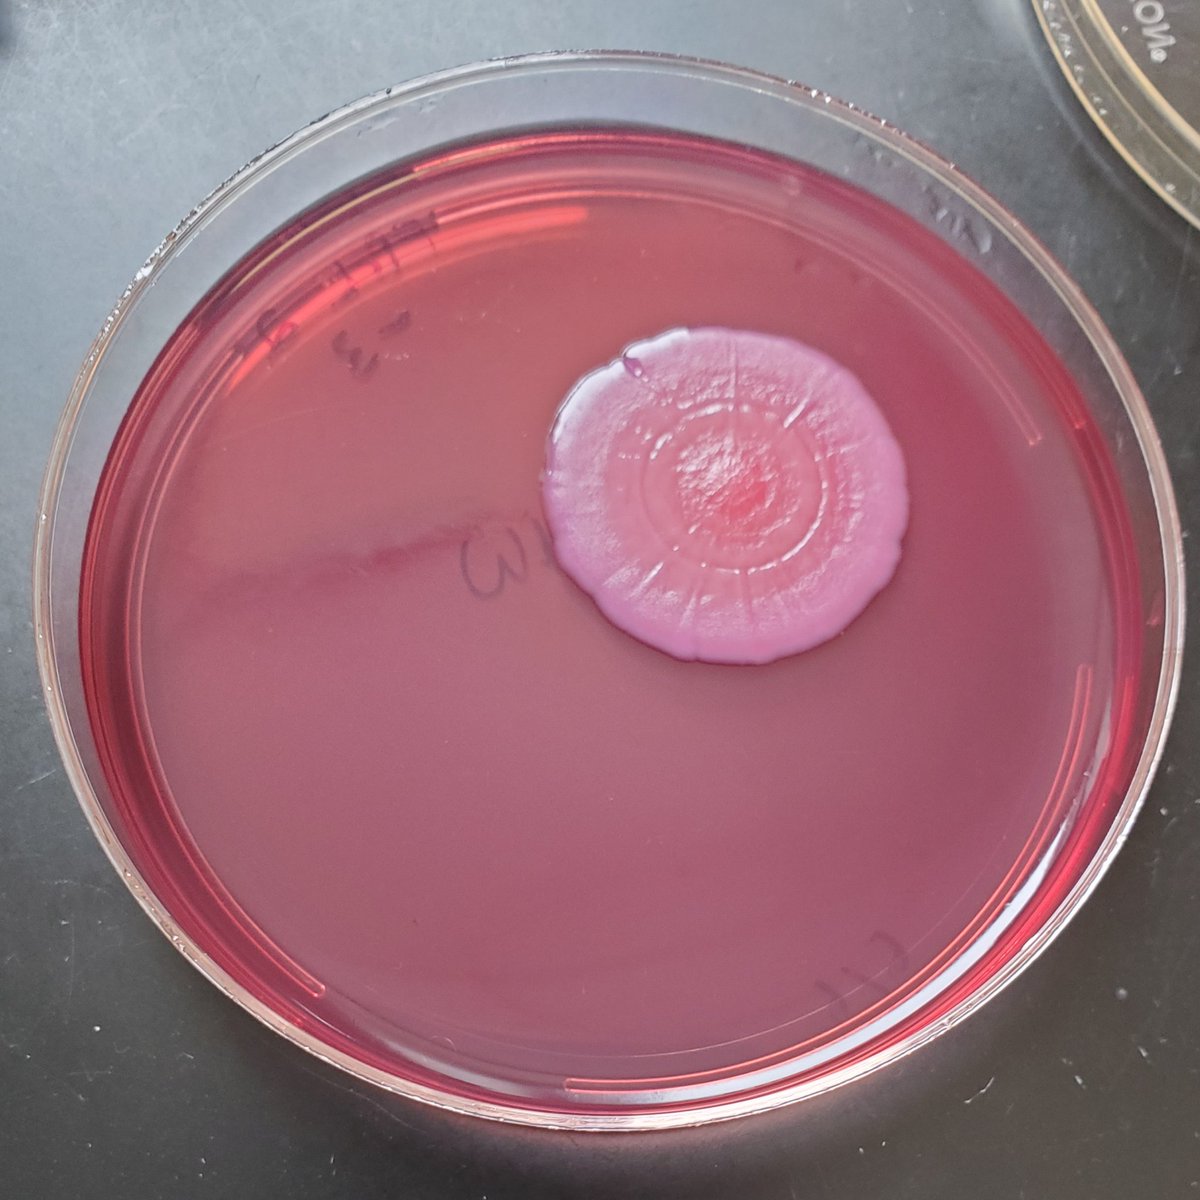
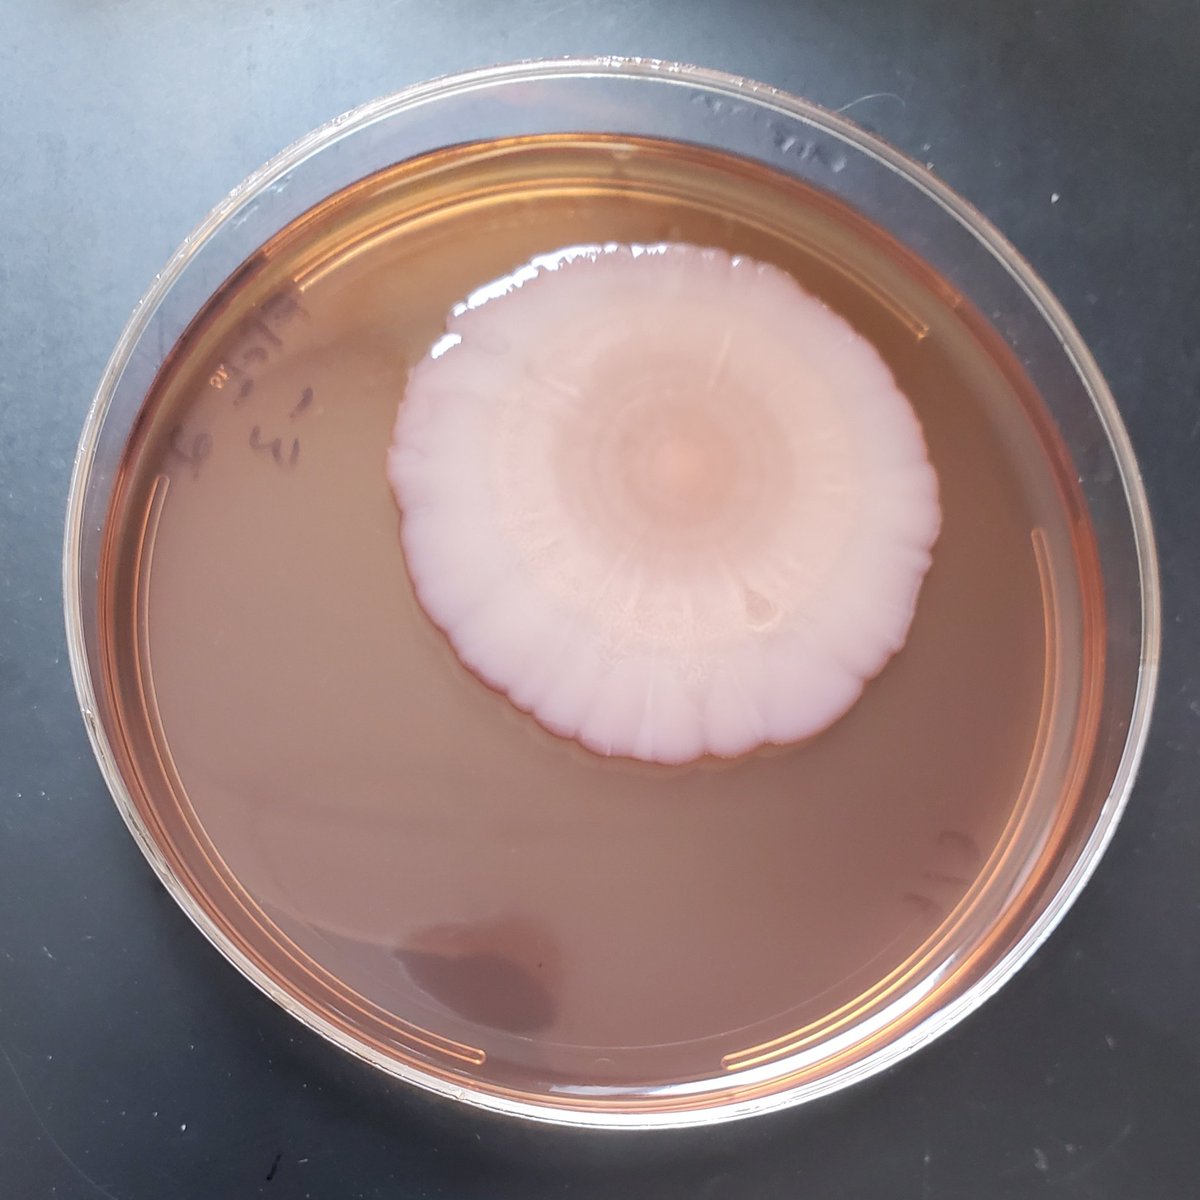
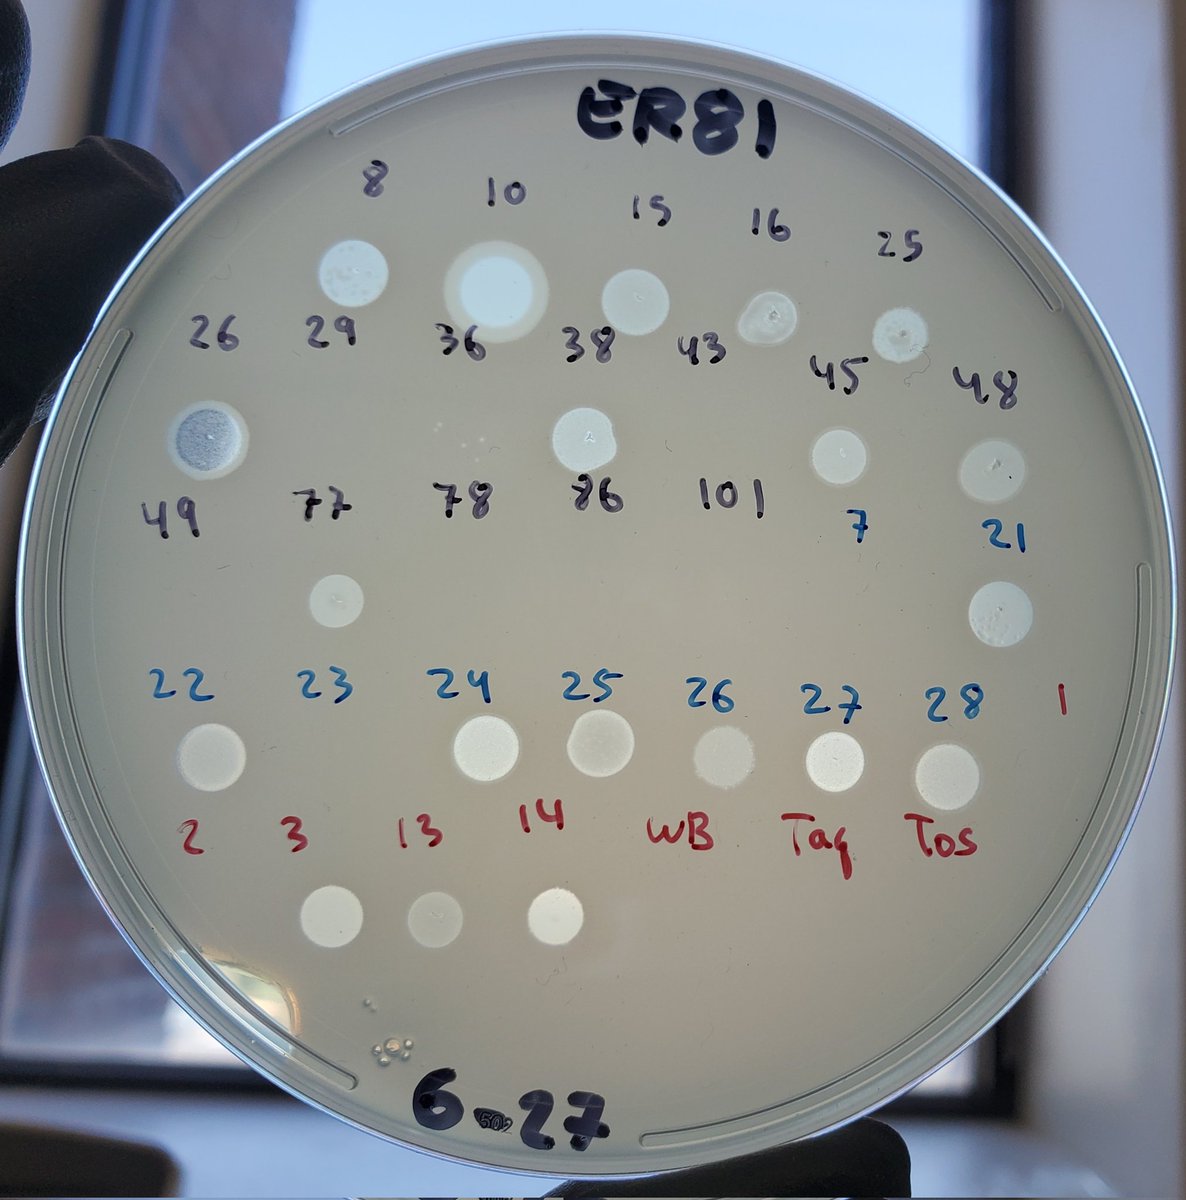
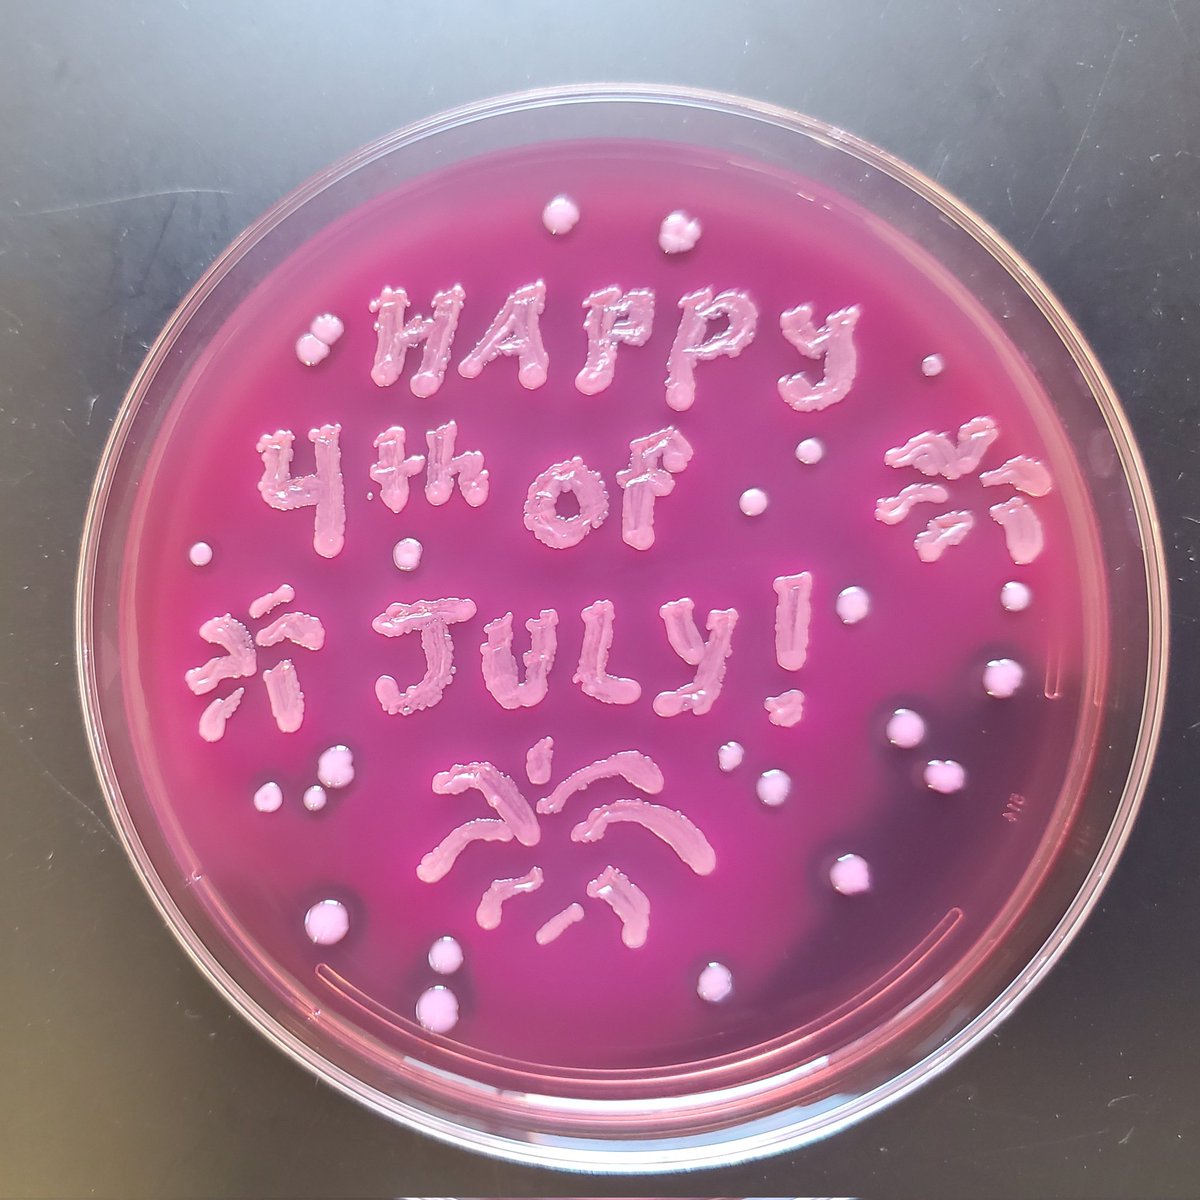
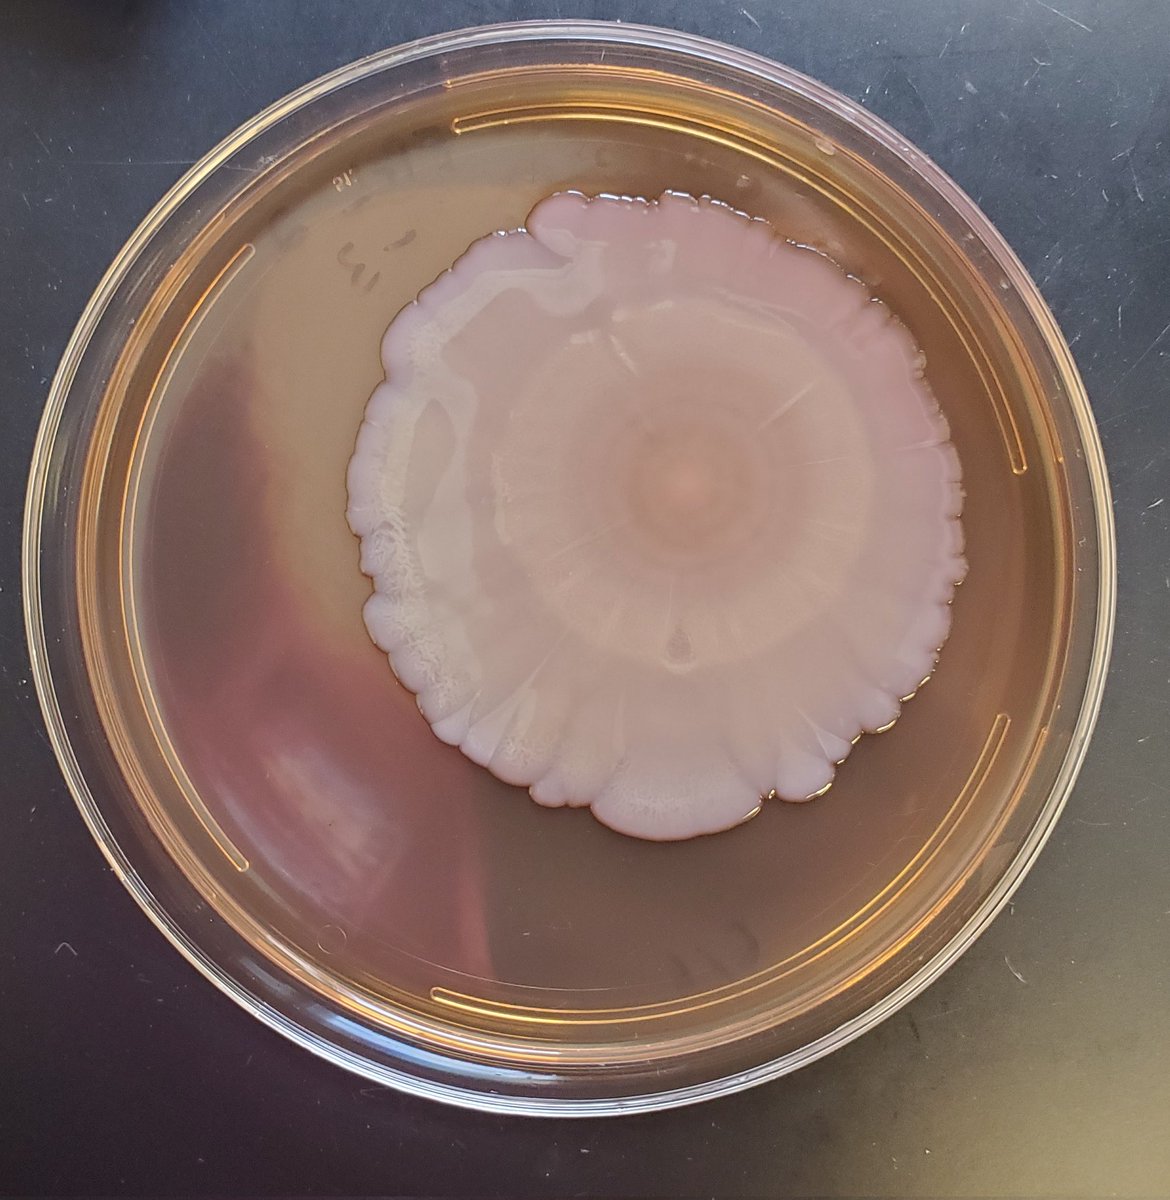
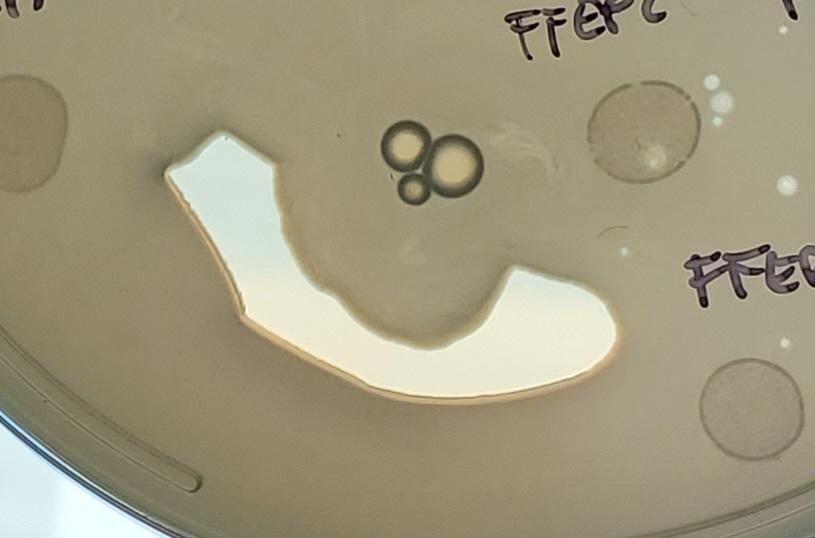
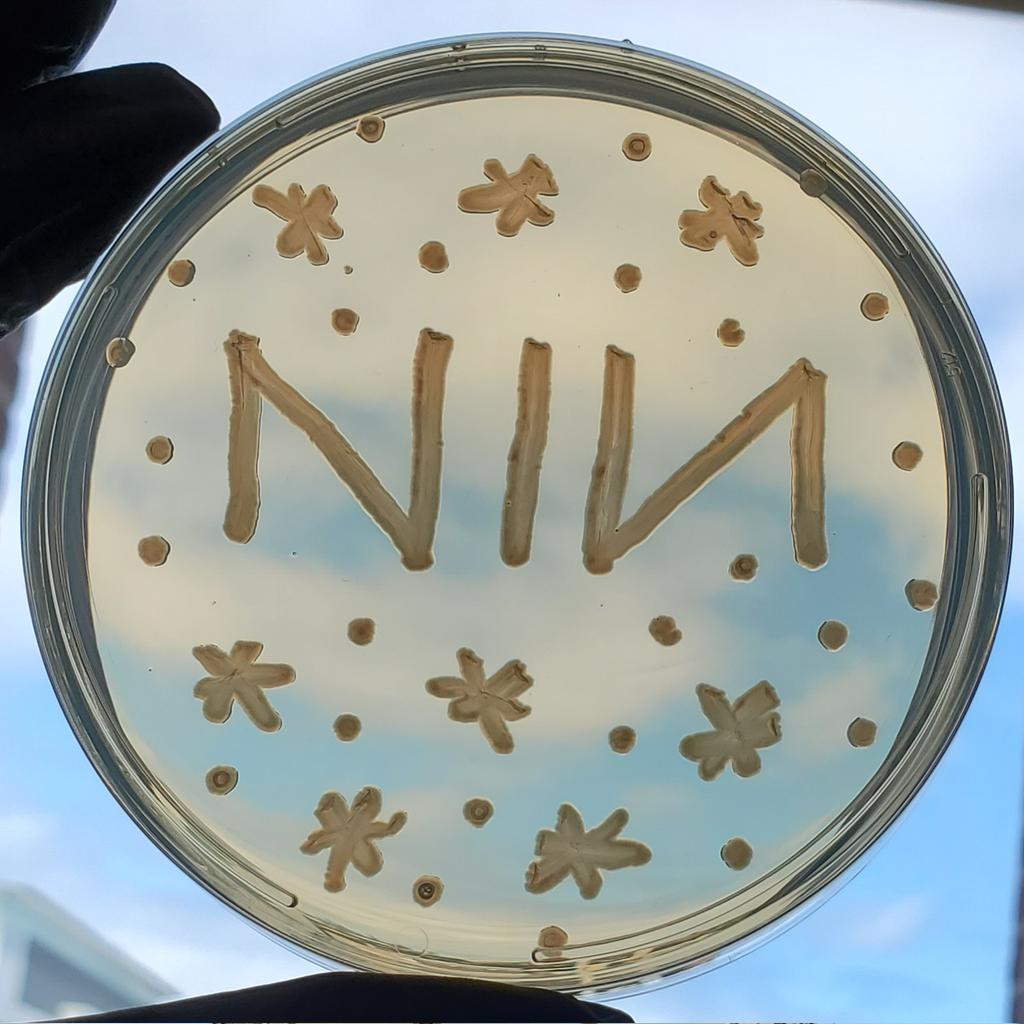

Ella Rotman
@klebsi_ella_r
Bacterial geneticist, agar artist, sci-fi fan, phage enthusiast, UChicago, #KlebClub
ID: 775737218333863936
13-09-2016 16:45:40
742 Tweet
817 Followers
261 Following

Getting ready for some artsy science outreach with Sebastian S. Cocioba🪄🌷's colorful plasmids, shown here in E. coli that has been streaked out all over a Petri dish.